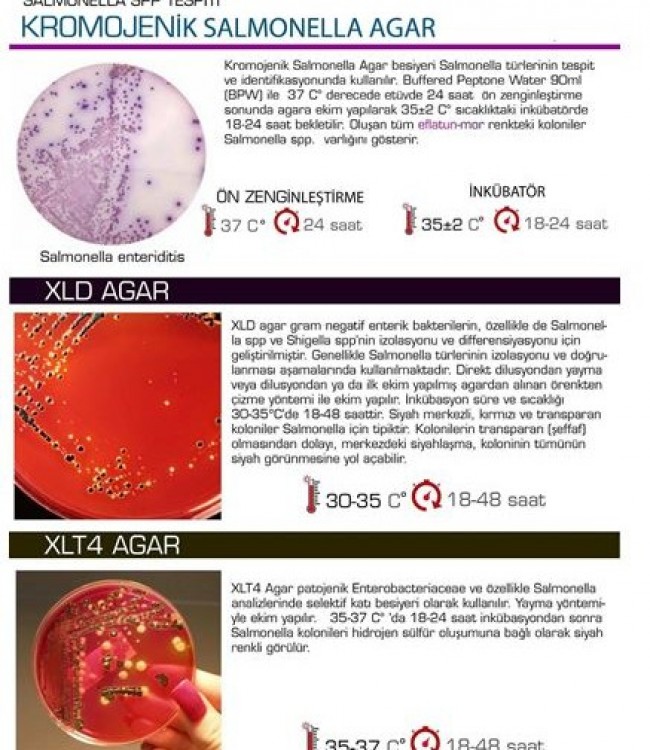

Kromojenik Salmonella Agar - Salmonella SPP Tespiti
SALMONELLA SPP TESPİTİ
KROMOJENİK SALMONELLA AGAR
Kromojenik Salmonella Agar besiyeri Salmonella türlerinin tespit ve identifikasyonunda kullanılır. Buffered Peptone Water 90ml (BPW) ile 37 C’de etüvde 24 saat ön zenginleştirme sonunda agara ekim yapılarak 35+-2 C sıcaklıktaki inkübatörde 18-24 saat bekletilir
Oluşan tüm efltun-mor renkteki koloniler Salmonella spp. varlığını gösterir.
XLD AGAR
XLD agar gram negatif enterik bakterilerin, özellikle de Salmonella spp ve Shigella spp’nin izolasyonu ve differensiyasyonu için geliştirilmiştir.
Genellikle Salmonella türlerinin izolasyonu ve doğrulanması aşamalarında kullanılmaktadır. Direkt dilusyondan yayma veya dilusyondan ya da ilk ekim yapılmış agardan alınan örnekten çizme yöntemi ile ekim yapılır.
İnkübasyon süre ve sıcaklığı 30-35C’de 18-48 saattir.
Siyah merkezli kırmızı ve transparan koloniler Salmonella için tipiktir.
Kolonilerin transparan (şeffaf) olmasından dolayı, merkezdeki siyahlaşma, koloninin tümünün siyah görünmesine yol açabilir.
XLT4 Agar
XLT4 Agar patojenik Enterobacteriaoeae ve özellikle Salmonella analizlerinde selektif katı besiyeri olarak kullanılır.
Yayma yontemiyle ekim yapılır. 35-37 C'da 18—24 saat inkübasyondan sonra
Salmonella kolonileri hidrojen sülfür oluşumuna bağlı olarak siyah renkli görülür.